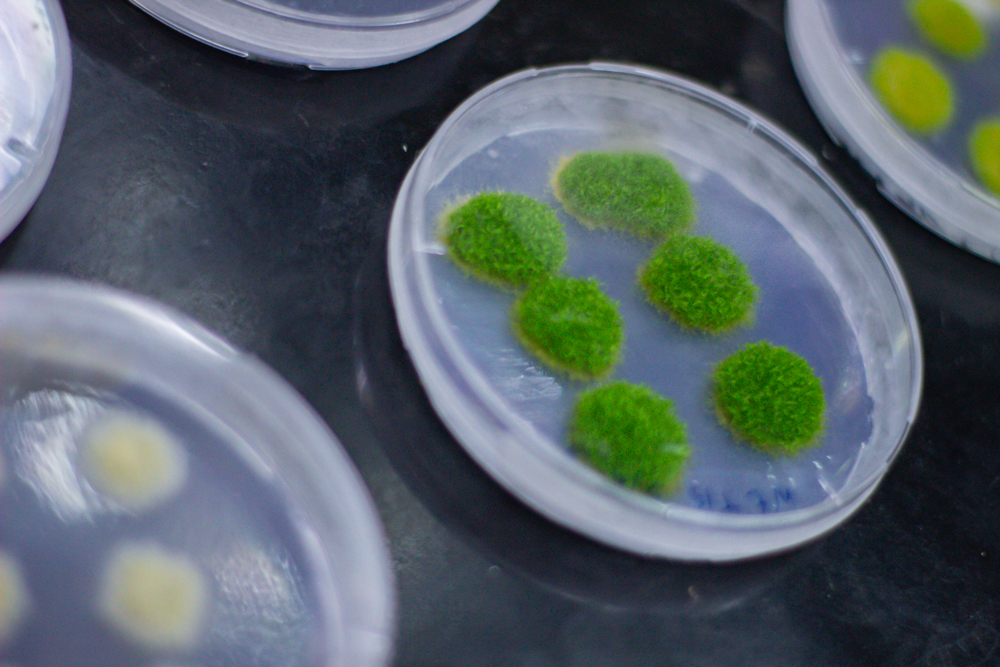
EDIT-177

Tras una jornada atravesada por la lluvia y el descenso de temperatura, la Noche de los Museos logró brillar nuevamente. En el Museo de Ciencias Interactivo (MCI), de la Facultad de Ciencias Químicas (UNC), más de 3.000 personas visitaron las 27 propuestas diseñadas para experimentar y aprender junto a familiares y amigos.
Desde la organización, destacaron el compromiso de las y los 160 integrantes de la Facultad –entre estudiantes, docentes y nodocentes- quienes durante meses fueron diseñando las diversas actividades. El viernes 7, desde las 20 y hasta las primeras horas de la madrugada del sábado, estuvieron coordinando los stands con juegos y experimentos ubicados en el Edificio Ciencias I.


En el Paseo Cultural del MCI, las y los visitantes también pudieron recorrer la exposición “Más allá de los límites: científicas de la FCQ” y la nueva muestra fotográfica “Paisajes de la Ciencia”.


Otra de las novedades de esta edición -la séptima en la que participó el MCI- fue la presentación oficial del coro Bromato de Armonio. El grupo formado por integrantes de la comunidad de la FCQ interpretó 3 piezas con acompañamiento instrumental de su director, Federico Velazco, estudiante del Doctorado en Ciencias Químicas.

“Una vez más, la gran convocatoria nos demostró que el museo tiene su propia identidad y constituye un puente con la sociedad, un espacio con el que la comunidad puede dialogar e interaccionar”, dijo Valeria Sueldo Occello, secretaria de Extensión.




Sueldo Occello también resaltó el rol de este evento en la FCQ: “Por un lado, fortalece la cultura científica, permitiendo profundizar sobre fenómenos muy interesantes, que ocurren a diario a nuestro alrededor o en nuestros cuerpos, pero a veces se desconocen. Asimismo, muestra la importancia de los desarrollos científicos para mejorar nuestra calidad de vida, convirtiéndose en una oportunidad para despertar vocaciones científicas entre quienes nos visitan, lo cual nos alegra”.
La Noche de los Museos en imágenes